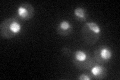
YDR412W

View description
Component of the pre-60S pre-ribosomal particle; required for cell viability under standard (aerobic) conditions but not under anaerobic conditions
Localization:
Intensity:
Fold change:
Significance:
-
C’ GFP library in SD
nucleus42.76 -
N' NOP1pr-GFP in SD

nucleolus157.666 -
N' TEF2pr-mCherry in SD

nucleus,nucleolus208.116 -
N' NATIVEpr-GFP in SD

below threshold19.4667 -
N' TEF2pr-VC and Cyto-VN in SD

#N/A0 -
C’ GFP library in SD+DTT

nucleus33.710.78No -
C’ GFP library in SD+H2O2

nucleus32.150.75No -
C’ GFP library in Starvation Media

punctateN/AN/AYes -
C’ GFP library on the background of Pup2-DaMP

nucleus -
C’ GFP library on the background of CCT mutant

nucleus45.77831.07033No
